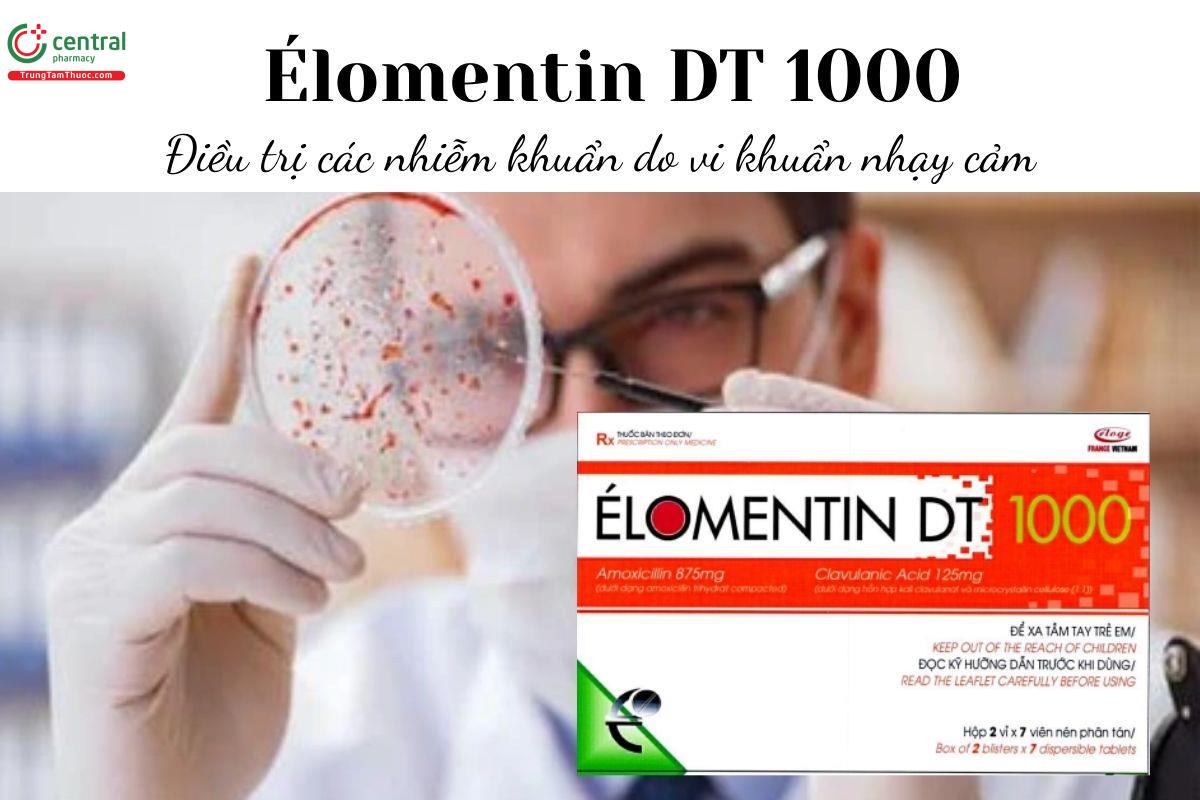
Thuốc Élomentin DT 1000 - Điều trị các nhiễm khuẩn do vi khuẩn nhạy cảm

Élomentin DT 1000
Thuốc kê đơn
Thuốc kê đơn quý khách vui lòng điền thông tin/ chat vào phần liên hệ này để dược sĩ tư vấn và đặt hàng
| Thương hiệu | Eloge France Việt Nam, Công ty cổ phần liên doanh dược phẩm Éloge France Việt Nam |
| Công ty đăng ký | Công ty cổ phần liên doanh dược phẩm Éloge France Việt Nam |
| Số đăng ký | 893110097925 |
| Dạng bào chế | Viên nén phân tán |
| Quy cách đóng gói | Hộp 1 túi x 2 vỉ x 7 viên |
| Hoạt chất | Amoxicillin, Acid Clavulanic |
| Xuất xứ | Việt Nam |
| Mã sản phẩm | hn619 |
| Chuyên mục | Thuốc Kháng Sinh |
Nếu phát hiện nội dung không chính xác, vui lòng phản hồi thông tin cho chúng tôi tại đây
- Chi tiết sản phẩm
- Hỏi & Đáp 0
- Đánh giá 0
1 Thành phần
Mỗi viên Élomentin DT 1000 chứa:
Amoxicillin: 875mg
Acid Clavulanic: 125mg
Tá dược: Vừa đủ
Dạng bào chế: viên nén phân tán. [1]
2 Tác dụng - Chỉ định của thuốc Élomentin DT 1000
Thuốc Élomentin DT 1000 được dùng để điều trị các nhiễm khuẩn do vi khuẩn nhạy cảm, bao gồm:
- Nhiễm khuẩn đường hô hấp trên (bao gồm cả viêm tai, viêm mũi, viêm họng), đường hô hấp dưới
- Nhiễm khuẩn đường tiết niệu
- Nhiễm khuẩn phụ khoa, lậu
- Nhiễm khuẩn da và mô mềm
- Nhiễm khuẩn xương khớp
- Viêm đường mật, viêm túi mật
- Hạ cam
- Nhiễm khuẩn răng miệng, ổ bụng hoặc bội nhiễm ổ bụng hậu phẫu.
- Một số nhiễm khuẩn Gram (+), Gram (-) và khuẩn kị khí nhạy cảm với thuốc.
==>> Xem thêm thuốc: Thuốc Hagimox capsules điều trị nhiễm trùng đường hô hấp trên
3 Liều dùng - Cách dùng thuốc Élomentin DT 1000
3.1 Cách dùng
Élomentin DT 1000 được dùng theo đường uống.
Có thể nuốt nguyên viên hoặc cho phân tán viên vào ½ cốc nước rồi lắc cho viên tan hết rồi uống.
3.2 Liều dùng
Người lớn và trẻ em cân nặng trên 40kg: 1 viên Élomentin DT 1000/ lần, 2 lần/ ngày.
Điều trị hạ cam: Uống liều 500mg amoxicillin và 125mg hoặc 250 mg acid clavulanic mỗi 8 giờ/ lần, thời gian điều trị trung bình các vết loét là 6,5 - 11,4 ngày và hết sưng hạch bạch huyết trong 4 tuần.
Điều trị lậu do N.gonorrhoeae sinh penicillinase hoặc không sinh penicillinase: Uống liều đơn chứa amoxicillin (3g) và acid clavulanic (125-500 mg) kết hợp hoặc không kết hợp với probenecid uống (1g).
Đối với bệnh nhân suy thận: không dùng cho bệnh nhân suy thận có Độ thanh thải creatinin dưới 30 ml/phút.
Đối với bệnh nhân suy gan: Thận trọng khi dùng, nên kiểm tra chức năng gan định kỳ.
4 Chống chỉ định
Chống chỉ định dùng Élomentin DT 1000 ở những bệnh nhân có tiền sử quá mẫn với bất kỳ thành phần nào của thuốc.
Chống chi định ở những bệnh nhân có tiền sử vàng da/ rối loạn chức năng gan liên quan đến amoxicillin - clavulanat, tiền sử dị ứng với beta lactam.
5 Tác dụng phụ
Tác dụng phụ thường gặp khi dùng Élomentin DT 1000: tiêu chảy, có nấm candida xuất hiện trên da và niêm mạc, buồn nôn, nôn.
Tác dụng phụ ít gặp: chóng mặt, đau đầu, tăng vừa phải AST và/ hoặc ALT, ngứa, mày đay.
Tác dụng phụ hiếm gặp: Giảm bạch cầu có hồi phục, kéo dài thời gian chảy máu và thời gian prothrombin, hội chứng giống bệnh huyết thanh,...
Tác dụng phụ chưa rõ tần suất: viêm màng não vô khuẩn, hội chứng Stevens-Johnson, hoại tử thượng bì nhiễm độc,...
6 Tương tác
Thuốc chống đông máu dạng uống: Nếu cần thiết kê toa đồng thời, nên theo dõi cẩn thận thời gian prothrombin hoặc INR khi bắt đầu hoặc ngưng dùng thuốc Élomentin DT 1000.
Các penicillin có thể làm giảm sự bài tiết methotrexat gây tăng nguy cơ độc tính
Probenecid làm giảm bài tiết amoxicillin qua ống thận do đó không khuyến cáo phối hợp
Mycophenonat moeftil, estrogen: Thận trọng khi sử dụng phối hợp.
7 Lưu ý khi sử dụng và bảo quản
7.1 Lưu ý và thận trọng
Nên uống thuốc với một lượng lớn nước để tránh khả năng tạo sỏi thận.
Không ngưng thuốc trước thời gian chỉ định, và không nên điều trị quá 14 ngày mà không kiểm tra tình trạng cho bệnh nhân.
Nên tránh sử dụng Élomentin DT 1000 nếu nghi ngờ tăng bạch cầu đơn nhân nhiễm khuẩn do sự xuất hiện của ban dạng sởi liên quan đến tình trạng này sau khi dùng amoxicillin.
Sự xuất hiện của sốt ban đỏ toàn thân kết hợp với mụn khi bắt đầu điều trị có thể là triệu chứng của hội chứng ngoại ban mụn mủ toàn thân cấp tính. Nếu phản ứng này xảy ra cần dừng ngay việc điều trị bằng Élomentin DT 1000 và chống chỉ định với việc sử dụng Amoxicillin.
Trong suốt quá trình điều trị bằng Amoxicillin, nên sử dụng phương pháp enzym khi thử Glucose nước tiểu vi phương pháp không enzym có thể gây kết quả dương tính giả.
Thận trọng khi sử dụng thuốc cho các bệnh nhân phải làm các công việc liên quan đến máy móc và lái xe.
7.2 Lưu ý sử dụng trên phụ nữ mang thai và bà mẹ cho con bú
Không dùng thuốc Élomentin DT 1000 cho các phụ nữ mang thai.
Đối với phụ nữ đang cho con bú: có thể được sử dụng trong thời kỳ cho con bú sau khi cân nhắc lợi ích/ nguy cơ bởi bác sĩ.
7.3 Xử trí khi quá liều
Kiểm tra sự cân bằng nước và điện giải cho bệnh nhân. Theo các báo cáo, thuốc Élomentin DT 1000 có thể được loại bỏ khỏi vòng tuần hoàn bằng thẩm phân máu.
7.4 Bảo quản
Bảo quản thuốc Élomentin DT 1000 ở nơi khô ráo, tránh ánh sáng mặt trời trực tiếp.
8 Sản phẩm thay thế
Trong trường hợp thuốc Élomentin DT hết hàng, quý khách có thể tham khảo các thuốc sau:
- Sản phẩm Vifamox 250 của Công ty Cổ phần Dược phẩm Trung ương VIDIPHA, chứa Amoxicilin kết hợp Kali clavulanat, là thuốc được sử dụng trong điều trị các nhiễm khuẩn do vi khuẩn nhạy cảm như viêm đường hô hấp, viêm tai mũi họng, nhiễm khuẩn da
- Sản phẩm Vidaloxin 250mg/1,5g do Chi nhánh Công ty Cổ phần Dược phẩm Trung ương Vidipha tại Bình Dương sản xuất, chứa Amoxicilin, được dùng trong nhiều tình huống nhiễm khuẩn do vi khuẩn nhạy cảm như viêm đường hô hấp, viêm tai giữa, nhiễm khuẩn da – mô mềm hoặc các nhiễm khuẩn tiết niệu
9 Cơ chế tác dụng
9.1 Dược lực học
Amoxicillin làm tế bào vi khuẩn suy yếu dựa vào khả năng làm gián đoạn quá trình tạo liên kết chéo của peptidoglycan - thành phần cấu trúc quan trọng của vách tế bào. Amoxicillin thường được phối hợp với acid clavulanic để mở rộng phổ tác dụng và khắc phục cơ chế đề kháng thuốc.
Acid Clavulanic có cơ chế tác dụng chính là gắn kết và bất hoạt không hồi phục các enzym beta-lactamase do vi khuẩn tiết ra. Nhờ cơ chế “bảo vệ kháng sinh”, acid clavulanic đóng vai trò tăng hiệu quả điều trị hơn là trực tiếp tiêu diệt vi khuẩn.
9.2 Dược động học
Amoxicillin có Sinh khả dụng cao giúp thuốc đạt được nồng độ điều trị ổn định trong máu và mô, đạt Cmax trong vòng khoảng 1–2 giờ sau khi uống. Thuốc ít bị chuyển hóa và phần lớn được thải trừ dưới dạng còn hoạt tính qua thận bằng lọc cầu thận và bài tiết ở ống thận.
Acid clavulanic được hấp thu qua đường uống tốt và nồng độ đỉnh trong huyết tương đạt được sau khoảng 1 giờ. Thuốc phân bố vào nhiều mô và dịch cơ thể tương tự amoxicillin, được chuyển hóa một phần tại gan thành các chất không còn hoạt tính kháng beta-lactamase.
10 Thuốc Élomentin DT 1000 giá bao nhiêu?
Thuốc Élomentin DT 1000 hiện nay đang được bán ở nhà thuốc online Trung Tâm Thuốc Central Pharmacy, giá sản phẩm có thể đã được cập nhật ở đầu trang. Hoặc để biết chi tiết về giá sản phẩm cùng các chương trình ưu đãi, bạn có thể liên hệ với dược sĩ đại học của nhà thuốc qua số hotline hoặc nhắn tin trên zalo, facebook.
11 Thuốc Élomentin DT 1000 mua ở đâu?
Thuốc Élomentin DT 1000 mua ở đâu chính hãng, uy tín nhất? Bạn có thể mang đơn mà bác sĩ có kê thuốc Élomentin DT 1000 để mua thuốc trực tiếp tại nhà thuốc Trung Tâm Thuốc Central Pharmacy tại địa chỉ: 85 Vũ Trọng Phụng, Thanh Xuân. Hoặc liên hệ qua số hotline/ nhắn tin trên website để được tư vấn sử dụng thuốc đúng cách.
12 Ưu điểm
- Thuốc Élomentin DT 1000 phối hợp amoxicillin và acid clavulanic giúp tác động lên nhiều vi khuẩn Gram dương và Gram âm, nâng cao khả năng điều trị trong các nhiễm khuẩn thường gặp.
- Dạng viên phân tán (DT) tiện lợi, có thể hòa tan trong nước trước khi uống, dễ sử dụng cho người khó nuốt viên nén.
13 Nhược điểm
- Thuốc Élomentin DT 1000 có thể gây ra một số tác dụng phụ như tiêu chảy, có nấm candida xuất hiện trên da và niêm mạc, buồn nôn, nôn,...
Tổng 8 hình ảnh









